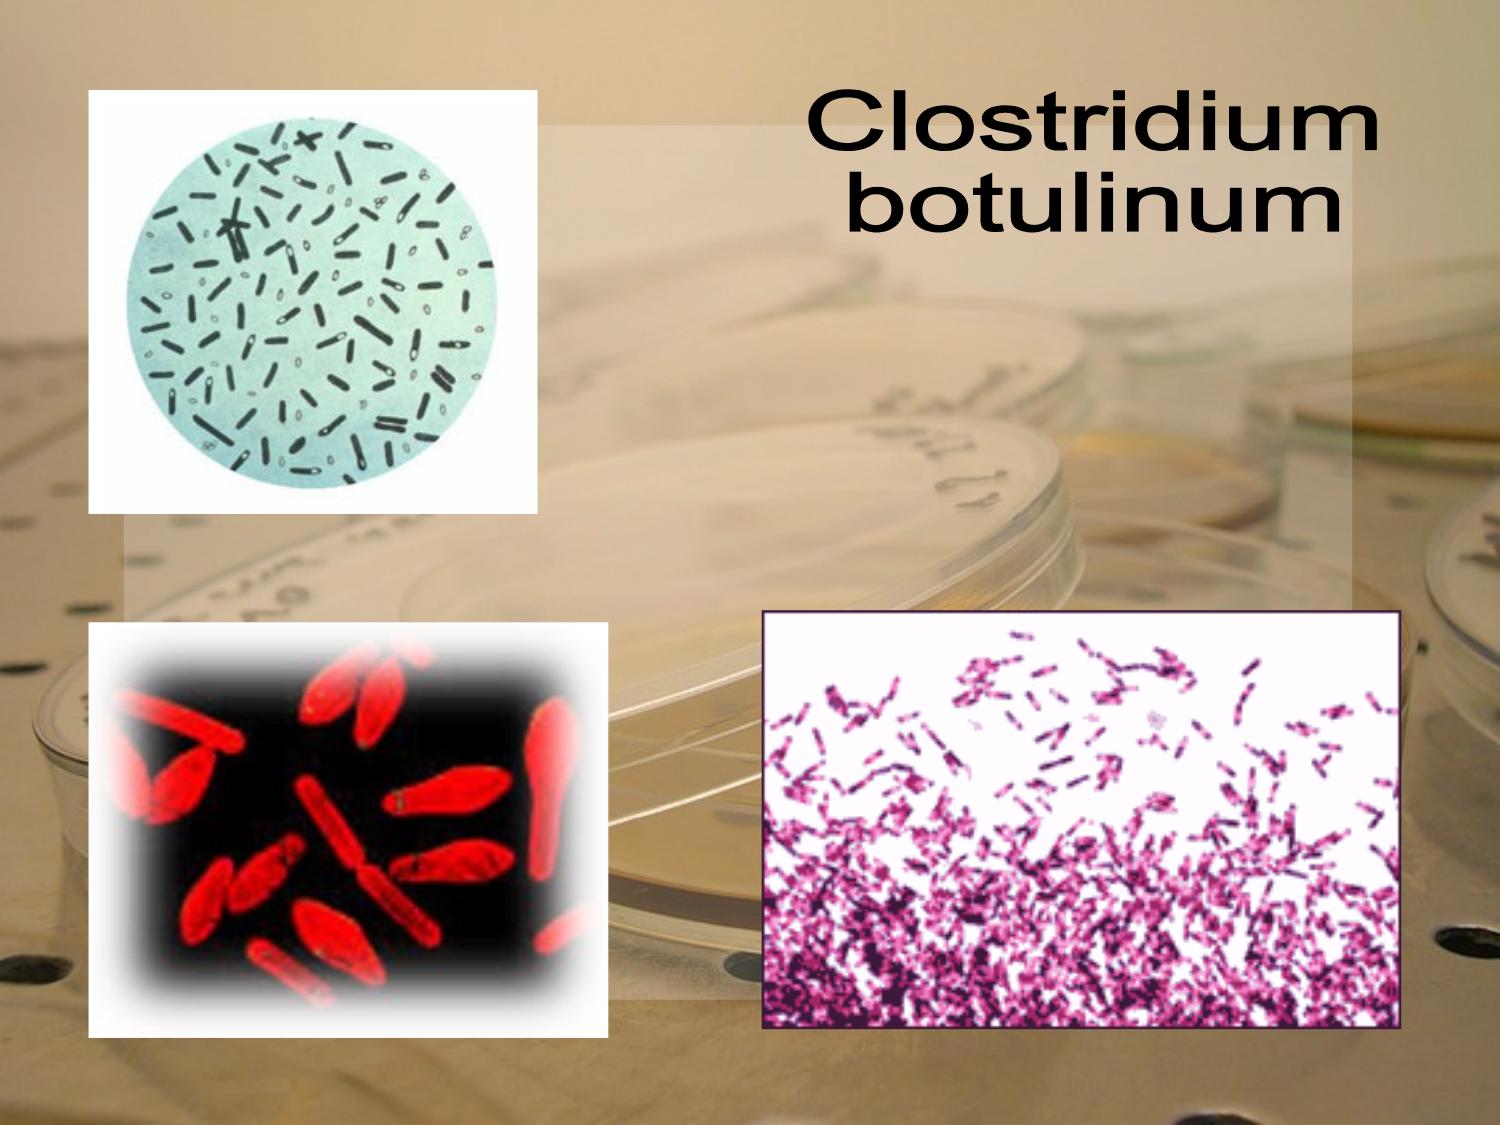

Ботулизм лечение
Длительность течения заболевания может составлять порядка около трех недель, что актуально при условии обеспечения требуемого лечения. Восстановление неврологической симптоматики производится в обратном порядке, сосредотачиваясь изначально на дыхании, а после – на глотании.
Другие проявления симптомов ботулизма излечиваются без какой-либо особой последовательности, возможно и их сохранение на протяжении длительного временного периода (порядка 1,5мес. и дольше). У пациентов, переболевших ботулизмом, все симптомы исчезают без следа, соответственно, и без каких-либо последствий. Если лечение не производится, то не исключается возможность летального исхода. Само лечение в частности заключается в нескольких этапах:
- Использование противоботулинической лошадиной антитоксической сыворотки, которая, в свою очередь, может быть моновалентной либо поливалентной (данный вариант актуален при неизвестном типе воздействующего ботулотоксина). Также может быть использован человеческий иммуноглобин (противоботулинический).
- С сывороткой, указанной выше в любом из ее вариантов вводится также преднизолон, чье действие призвано исключить возможность развития анафилактического шока. Также, для недопущения последнего проявления до введения сыворотки проводится проба с использованием малых доз, впоследствии чего, если не возникает аллергическая реакция, то доза преднизолона увеличивается.
- В результате актуального для больных пареза повышается риск закупорки у них дыхательных путей и развития дыхательной недостаточности. Эти факторы являются угрозой для жизни, а потому необходимо обеспечить больным парентеральное и зондовое питание при одновременном подключении их к аппарату искусственной вентиляции легких.
- В случае актуальности поражения миокарда предписываются цитопротекторы.
- Бактериальные осложнения требуют использования антибиотиков широкого спектра действия.
- Ранние стадии заболевания предусматривают необходимость воздействия на возбудителя также и посредством ЖКТ, что достигается за счет очистительных клизм, промывания желудка и назначения сорбентов.
Дополнительно назначается диета (№10), из рациона исключаются блюда, насыщенные экстрактивными составляющими, а также жирные продукты и пряности. Предписывается также полупостельный/постельный режим.
Важным моментом, который следует выделить в качестве итога нашей статьи, является необходимость немедленного вызова «скорой помощи» при признаках пищевого отравления (тошнота и рвота, боль в животе) в комплексе с выраженной мышечной слабостью, речевыми и зрительными нарушениями, а также с глотательными нарушениями. В противном случае промедление и исключение такой помощи может привести к летальному исходу!
Первая помощь при ботулизме (отравлении с подозрением на это заболевание) заключается, помимо вызова скорой, в даче больному большого количества жидкости и обеспечении ему доступа к свежему воздуху. В случае остановки дыхания необходимо перейти к процедуре искусственного дыхания
Также важно найти, по возможности, остатки той пищи, которая была до наступления такого состояния съедена больным – это необходимо для проведения лабораторных анализов
В любом случае требуется консультация инфекциониста.
Врачи подчеркивают, что инкубационный период ботулизма может варьироваться от 12 часов до нескольких дней, в зависимости от количества токсина, попавшего в организм, и индивидуальных особенностей пациента. Наиболее часто симптомы начинают проявляться через 18-36 часов после употребления зараженной пищи. Важно отметить, что ранняя диагностика и своевременное лечение играют ключевую роль в снижении риска серьезных осложнений. Врачи рекомендуют быть особенно осторожными с консервированными продуктами домашнего приготовления, так как они могут содержать споры бактерий, вызывающих ботулизм. Профилактика, включая соблюдение правил хранения и обработки продуктов, остается основным способом предотвращения заболевания.
https://youtube.com/watch?v=c3IlGLM0Xb8
Определение.
Ботулизм — инфекционная болезнь, возникающая под действием специфического белкового нейротоксина, продуцируемого микроорганизмами — Clostridium botueinum. Сейчас известны 3 принципиально различные формы болезни: пищевой наиболее распространенный и редкие формы — раневой и ботулизм новорожденных.
Актуальность.
Ботулизм является эндемичной патологией, встречающейся ежегодно на территории Беларуси, нередко приводящей к летальным исходам.
Характеристика возбудителя.
Clostridium botulinum анаэробная, подвижная, спорообразующая палочка, способная продуцировать самый сильный из всех известных в науке токсинов. Палочка с закругленными краями, длиной 5- 10 мкм, шириной 0,3-0,4 мкм с 3-20 жгутиками. По антигенным свойствам, которые присущи и возбудителю и токсину известны 7 типов возбудителя: А, В, С, Ср, D, Е, F, G.
Оптимальные условия роста вегетативных форм -— крайне низкое остаточное давление кислорода и температурный режим в пределах 28-35°С, кроме типа “Е”— 3°С условия холодильника. В то же время при прогревание 80°С в течение 30 мин вызывает их гибель.
В неблагоприятных условиях вегетативные формы возбудителей ботулизма образуют споры. Они чрезвычайно устойчивы к различным физическим и химическим факторам, выдерживают кипячение в течение 4-5 часов, воздействие различных дезинфицирующих средств в высоких концентрациях, сохраняются в продуктах, содержащих до 18% поваренной соли. Интерес представляет феномен образования из вегетативных форм Clostridium bolulinum так называемых «дремлющих спор», при недостаточном их прогревании, способных к прорастанию лишь через 6 месяцев. Споры устойчивы к замораживанию и высушиванию, к прямому ультрафиолетовому облучению.
В анаэробных или близких к ним условиях возбудители ботулизма про дуцируют специфический летальный нейротоксин, являющийся единственным, исключительным по силе, фактором патогенности. Ботулинические токсины белковой природы в обычных условиях внешней среды сохраняются до года в консервированных продуктах — годами. Они устойчивы в кислой среде, не инактивируются ферментами пищеварительного тракта. Токсические свойства ботулотоксина Е под влиянием трипсина могут усиливаться в сотни раз Ботулинические токсины выдерживают высокие концентрации (до 18%) поваренной соли, не разрушаются в продуктах, содержащих различные специи. Токсины сравнительно быстро инактивируются под влиянием щелочей, при кипячении полностью теряют свои токсические свойства в течение нескольких минут, а под воздействием небольших концентраций марганцовокислого калия, хлора или йода — в течение 15-20 мин. Присутствие ботулотоксина в пищевых продуктах не изменяет их органолептических свойств.
Диагностика
Подтвердить или опровергнуть диагноз можно только обнаружением токсина. Во всех остальных анализах нет никаких специфических признаков, которые указывали бы на ботулизм.
Исследуют биологические жидкости: рвотные и фекальные массы, раневое отделяемое, промывные воды желудка. Если есть конкретное подозрение на пищу, то исследуют и ее.
Из крови пациента методом центрифугирования выделяют плазму и вводят ее белым мышам. Одновременно им вводят противоботулиническую сыворотку разных серотипов. За грызунами наблюдают 4 дня. Те мыши, которым была введена сыворотка подходящего серотипа, остаются живы, остальные погибают.
Инкубационный период ботулизма вызывает множество обсуждений среди людей, особенно в контексте пищевой безопасности. Многие отмечают, что симптомы могут проявляться через 12-36 часов после употребления зараженной пищи, что делает диагностику сложной. Некоторые делятся личными историями о том, как быстро развивались признаки отравления, что подчеркивает важность своевременного обращения за медицинской помощью. В социальных сетях активно обсуждаются меры предосторожности, такие как правильная консервация и хранение продуктов. Люди также акцентируют внимание на том, что даже небольшое количество токсина может быть опасным, что подчеркивает необходимость повышения осведомленности о ботулизме. В целом, обсуждения вокруг инкубационного периода подчеркивают важность образования и профилактики в борьбе с этим опасным заболеванием.
https://youtube.com/watch?v=Nh9PsyoyhGQ
Причины ботулизма. Способы передачи
В качестве источников и резервуаров инфекции ботулизма выступает почва, а также синантропные животные, то есть синантропы — существа, обитающие как совместно с людьми в масштабах их жилищ, так и существа, находящиеся в непосредственной от них близости, а именно наружные и внутренние паразиты (комары, клещи, гельминты, блохи и пр.), мыши, крысы, воробьи, ласточки и т.д. Также сюда относится рыба, водоплавающие птицы и собственно люди.
Если носителем возбудителя данного заболевания является животное, то видимого для него вреда под воздействием инфекции не оказывается. Что касается непосредственно больных лиц, то для тех, кто их окружает, эпидемиологически опасными они не являются.
Выделение бактерий из зараженного организма в любых вариантах происходит фекальным или оральным путем при последующем попадании их в воду, почву и пр. Внешняя среда по части отдельных своих элементов может загрязняться через разложение погибших от рассматриваемого заболевания птиц и грызунов (то есть непосредственно через их трупы). Собственно механизм передачи заболевания является фекально-оральным.
Что касается причин ботулизма, то они заключаются в употреблении таких продуктов в пищу, как домашняя консервация (в особенности это овощи и грибы), ветчина, рыба (соленая, копченая), колбасы. Почти все те продукты, которые подверглись почвенному загрязнению либо загрязнению посредством содержимого кишечника животных, рыб и птиц, содержат в себе споры возбудителя заболевания, рассматриваемого нами.
Ботулизм у новорожденных, а также раневой ботулизм встречаются гораздо реже. В первом случае заболевание возникает на фоне попадания в кишечник клостридий при последующей выработке ими в нем токсина, во втором случае за счет отсутствия доступа кислорода при ранах некротизированного и размозжённого типа создаются приближенные к анаэробным условия, в результате чего в них начинают прорастать споры при последующей аккумуляции ботулотоксина.
Примечательно, что хорошее всасывание токсина отмечается не только при рассмотрении этого процесса в рамках слизистой ЖКТ, но также и при таком процессе, актуальном для глазных слизистых и слизистых верхних дыхательных путей. Это, в свою очередь, определяет соответствующую опасность токсина при возможном его применении в качестве оружия биологического типа.
Если говорить о восприимчивости к ботулизму людей, то она, как можно заметить, достаточно высока. Учитывая тот факт, что активность токсина происходит в рамках минимальных доз, то это, в свою очередь, исключает возможность появления соответствующих иммунных реакций со стороны организма, соответственно, иммунитет в отношении такого воздействия просто не вырабатывается.
Профилактика и мероприятия в очаге.
Профилактика ботулизма основана на строгом соблюдении правил приготовления и хранения рыбных и мясных полуфабрикатов, консервированных продуктов, копченостей и т. п. Поэтому перед употреблением таких продуктов их целесообразно прокипятить в течение 10-15 минут, чем достигается полная нейтрализация ботулинических токсинов.
При выявлении случаев заболевания подозрительные продукты подлежат изъятию и лабораторному контролю, а употреблявшие их лица вместе с заболевшими — медицинскому наблюдению в течение 10-12 дней. Целесообразно внутримышечное введение им по 2000 ME антитоксических противоботулинических сывороток А, В и Е, назначение энтеросорбентов. Активная иммунизация осуществляется только лицам, имеющим или могущим иметь контакт с ботулотоксинами. Прививки проводят полианатоксином трехкратно с интервалами 45 суток между 1-й и 2-й и 60 суток между 2-й и 3-й прививками. В профилактике ботулизма существенное значение имеет санитарное просвещение населения в отношении приготовления продуктов питания, которуе могут стать причиной отравления ботулотоксинами.
Структура ответа. Определение, актуальность, характеристика возбудителей, эпидемиология, патоморфогенез, клиника, диагностика, лечение, профилактика.
https://youtube.com/watch?v=RGdvySvQ7h0
Более новые статьи:
- Сальмонеллез — Актуальность, клиника, диагностика — 17/08/2012 16:00
- Пищевые токсикоинфекции — определение, актуальность, лечение — 17/08/2012 16:00
- Холера — определение, актуальность, характеристика возбудителей, эпидемиология, патоморфогенез, классификация, клиника, классификация холеры, оценка степени обезвоживания, диагностика, принципы лечения больных холерой. — 17/08/2012 15:59
Более старые статьи:
- Вирусные гепатиты А и Е — определение, актуальность, характеристика возбудителей, эпидемиология, патогенез, классификация, клиника, диагностика, лечение, профилактика. — 17/08/2012 15:57
- Вирусные гепатиты с парентеральным механизмом заражения (В, С, D, G, ТТ, SEN) — определение, актуальность, характеристика возбудителей, эпидемиология, патоморфогенез, классификация, клиника, диагностика, лечение, профилактика. — 17/08/2012 15:56
- Сыпной тиф и болезнь Брилла — определение, актуальность, характеристика возбудителей, эпидемиология, патоморфогенез, классификация, клиника, осложнения, диагностика, лечение, профилактика. — 17/08/2012 15:55
Раневой ботулизм, младенческий ботулизм основные особенности
Как мы уже отметили, эти формы ботулизма встречаются не так часто. Между тем, имеются определенные характерные для них особенности:
- заражение происходит спорообразующими, а не вегетативными формами;
- отмечается длительность течения инкубационного периода;
- отсутствует гастроэнтеритический период в течении заболевания;
- симптомы ботулизма у новорожденных проявляются в слабости сосания либо и вовсе в отказе от него, в вялости и в задержке стула, в ослаблении сосательного или глотательного рефлексов, актуальна и офтальмологическая (выше — «глазная») симптоматика заболевания, плач хриплый;
- осложнения у детей (например, в форме пневмоний), отмечаются значительно чаще, кроме того, чаще среди них отмечаются и летальные исходы.
Лечение ботулизма
Всех без исключения больных, при малейших подозрениях на ботулизм, необходимо незамедлительно госпитализировать в инфекционный стационар для проведения неотложной специфической терапии, направленной на предупреждение возможных тяжелых осложнений. Первоочередными задачами неотложной терапии являются обеспечение функций сердечно – сосудистой и дыхательной систем организма, а также нейтрализация, связывание и последующее выведение токсинов из организма. В случае присоединения параличей или парезов мышц гортани и глотки, значительно усиливается дыхательная недостаточность при ботулизме. Это способствует серьезному ухудшению проходимости дыхательных путей, а также развитию ателектазов и аспирационной пневмонии. Поэтому еще на догоспитальном этапе следует провести такие неотложные мероприятия как: промывание желудка, первоначально кипяченой водой, а затем 2% р-ром гидрокарбоната натрия; дать больному солевое слабительное (на 500 мл воды 30 гр сернокислой магнезии), а далее энтеросорбенты (энтеродез, полифепан и пр.); сделать очистительную клизму с полифепаном или 2-4% р-ром гидрокарбоната натрия; назначить частое обильное питье с введением диуретиков (гипотиазид, лазикс и пр.).
В особо тяжелых случаях необходимо проведение инфузионной дезинтоксикационной терапии с форсированием диуреза, введением гуанидина гидрохлорида по 20-35 мг/кг/сутки. При острой дыхательной недостаточности проводится искусственное дыхание. При параличе дыхания, пациент переводится на искусственную вентиляцию легких. С целью нейтрализации ботулотоксина применяются лечебные моновалентные противоботулинические сыворотки. Так как в ЖКТ, споры могут трансформироваться в вегетативные формы, показано проведение антибактериальной терапии: препараты тетрациклинового ряда или левомицетин.
Даже в случае своевременного оказания квалифицированной медицинской помощи, выздоровление больных при ботулизме проходит достаточно медленно. Остаточные явления после параличей могут наблюдаться еще на протяжении одного – двух месяцев
Предупреждение ботулизма
Перед употреблением необходима тщательная проверка консервированных продуктов, обязательное изъятие «бомбажных» (надутых) банок. Перед употреблением необходимо прогревать (100*С — 30 мин.) приготовленные в домашних условиях грибные, мясные и овощные консервы.
После отбора проб для проведения лабораторных исследований, продукты послужившие причиной заражения, необходимо изъять и уничтожить. Столовая посуда, которая контактировала с зараженными продуктами, а также белье загрязненное выделениями больного, подвергаются тщательной дезинфекции. Людям, употреблявшим вызвавшие заболевание продукты, показано обязательное введение противоботулинической сыворотки с последующим медицинским наблюдением на протяжении не менее десяти суток.
Как и почему наступает отравление
Пока бактерии и споры Clostridium botulinum живут в окружающей среде (почве, иле, воде) они не опасны для человека.
- Едва они попадают в организм с продуктами (вместе с землей, илом, песком) то быстро активизируются. Обычно это происходит при недостаточной термообработке в глубине слоев мякоти подвяленной рыбы, мяса, тушенке, а также плодах, овощах, грибах, консервированных без добавления кислоты.
- В процессе жизнедеятельности патогенные Клостридии ботулизма начинают вырабатывать сильнейший яд (ботулин), разрушающий клетки крови и нервной системы. Происходит отключение нейромышечных связей, у человека может остановиться дыхание и отказать сердце.
Минимальной порции ботулотоксина, который может накопиться в банке тушеного мяса, рыбной консервы или соленых рыжиков менее чем за 1 месяц, достаточно для отравления всех, кто просто попробовал продукты – настолько высока скорость образования токсина.
Как распознать банки с ботулизмом? Визуально это практически невозможно. Если в консервах промышленного производства критерием оценки доброкачественности продукта становятся вздутые крышки, смешанная рыхлая консистенция продукта, то в домашних заготовках заметить порчу сложно – внешний вид тары может остаться неизменным.

Возбудитель болезни
Возбудитель ботулизма – анаэробная бактерия, палочка из рода клостридий, которая под электронным микроскопом имеет вид теннисной ракетки. При этом в той части, что похожа на расширение ракетки, находятся споры. Палочки не имеют капсулы, очень подвижны, в биологическом материале располагаются цепочкой или в виде скоплений. Исследователи выделяют 7 серологических типов, наиболее опасны из которых типы А, В, Е и F.
Палочка ботулизма постоянно присутствует в почве, растительных и животных остатках.
Устойчивость возбудителя ботулизма просто поражает. Вегетативная форма выдерживает 30-минутное кипячение, после чего может перейти в споровую форму, которой не страшно кипячение более 6 часов. Ни соль, ни специи, ни замораживание, ни соляная кислота, содержащаяся в желудке, на споры никак не действует.
Сама по себе палочка ботулизма не опасна для человека и животных. Если здоровый человек или животное проглатывает такую палочку, то она выводится естественным путем, не причиняя вреда. Происходит это потому, что для размножения палочке необходимы анаэробные условия или отсутствие кислорода при температуре от 28 до 35С.
Размножается палочка в герметичных консервных банках, в загрязненных землей ранах и кишечнике детей до 6 месяцев, у которых еще нет естественной защиты. Болезнь вызывается не самой палочкой, а ее токсином, который по своим ядовитым свойствам сильнее яда гремучей змеи более чем в 300 раз.
Ботулотоксин – сильнейшее биологическое оружие, способное всасываться через слизистую глаз и носа, имеющее колоссальную поражающую силу.
Но из него же изготавливают препараты «Ботокс» и «Диспорт», используемый косметологами для блокирования мимических мышц и разглаживания морщин. Все дело в том, что яд действует только в точке применения. В случае ботулизма поражаются синапсы, в которых передача нервного импульса переходит с нейронов на мышцы посредством ацетилхолина, который и перестает выделяться в синаптическую щель. В результате возникает «блок» нервно-мышечной передачи. В случае с Диспортом это воздействие локально расслабляет мышцы там, где нужно, а в случае с ботулизмом речь идет о множестве локализаций, из которых самая опасная – дыхательная мускулатура.
Как происходит заражение?
Пути передачи – фекально-оральный и контактный, но выделяют еще воздушно-пылевой, который реализуется у младенцев до 6-ти месяцев от роду.
Природный резервуар – почва, водоемы со стоячей водой, силосные ямы, трупы павших животных, откуда возбудитель попадает в организм. Далее происходит развитие возбудителя с выделением токсина. Такие пути передачи встречаются нечасто.
Самый распространенный инфекционный путь – пищевой, когда человек ест консервы, содержащие ботулотоксин. Но второе название заболевания – «колбасный яд». Размножаться палочка может в толще колбасы, в мясе копченой рыбы, везде, где нет доступа кислорода. Но такие места размножения встречаются «пятнами» в одном и том же продукте. Вот почему, из пяти человек, которые ели колбасу, могут заболеть один, два, или как выпадет случай.
Определить наличие токсина ни на вкус, ни по внешнему виду невозможно, ничего не изменяется. Единственный признак – вздувшаяся крышка или раздутая металлическая банка («бомбаж»), но его может совершенно не быть. Раздувание происходит газами, которые образуются при размножении. Такое бывает при домашнем консервировании, в промышленных условиях продукты подвергаются автоклавированию при 120С, только при таком режиме возбудитель погибает.
На первом месте по опасности находятся консервированные грибы, далее следует мясо, рыба, приправы (чеснок, зелень, перец чили) в растительном масле без добавления кислот.
Заражение может происходить также при вдыхании аэрозоля, содержащего ботулотоксин, через кожные ранки и царапины. Больной ботулизмом человек не является источником инфекции.
Признаки и симптомы ботулизма
В этом случае инкубационный период удлиняется, так как необходимо время, чтобы протоксин под действием пищеварительных ферментов превратился в ботулотоксин.
Начало патологии может быть постепенным, со смазанной клинической картиной и многочисленными симптомами, это приводит к неверно поставленному диагнозу, что отнимает необходимое для экстренных мер время.
Чаще всего патология начинается выраженно с:
- диспепсических расстройств;
- нарушения зрения;
- угнетения функции дыхания.
Характерные для ботулизма признаки и причины их возникновения перечислены в таблице:
| Признаки токсикоинфекции | Причины возникновения | Последствия |
| Нарушение дыхательной функции – прерывистое, неглубокое | Снижение силы в мышцах ответственных за процесс дыхания | кислородное голодание смешанного генеза |
| Мышечная атония, паралич | блокирование транспорта нервных импульсов | кислородное голодание, нарушение метаболизма |
| Аритмия, сбои в работе сердца, повышенное артериальное давление | повышенная активность симпатической НС, гипоксия | нарушение функций миокарда |
| Гипосаливация, нарушение глотания, изменение фонации, носовое звучание, частичный паралич языка | Интоксикация ганглиев V, IX, XIIнервов черепа | парезы и параличи мышц |
| Невозможность вращения глазами, диплопия, птоз | Токсическое поражение ганглиев III, IVнервов черепа | парезы и параличи мышц органа зрения |
| Мидриаз, нарушение четкости зрения, аккомодации | интоксикация тройничного нерва | парезы и параличи мышц органа зрения |
| Отсутствие мимики | Интоксикация ганглиев лицевых нервов | — |
| Метиоризм, отсутствие эвакуаторной функции | Нарушение функции блуждающего нерва | снижение перистальтики кишечника, нарушение функции пищеварения |
| Рвота, часто повторяющийся понос | локальное действие токсина, действие инородной микрофлоры | нарушение обмена веществ, истощение, дегидратация, дисбаланс нутриентов |
| Задержка мочеиспускания | расслабление мочевого пузыря и мышц промежности | — |
| Бледные кожные покровы | Спазм кожных сосудов | — |
В случае преобладания нарушения функции пищеварительной системы ботулизм начинается с ощущения тошноты, к которому в скором времени присоединяется рвота, отмечающаяся в начале болезни. Больной жалуется на приступообразные, иногда сильные боли снизу грудины, ощущение дискомфорта в области желудка.
Одновременно развивается гипосаливация – пересыхание слизистых рта и ощущение сильной жажды. Характерными в этот период заболевания являются метеоризм, запоры, которые из-за пареза мышц кишечника могут быть стойкими. Но иногда в самом начале заболевания у больных отмечается послабление стула.
К ранним признакам ботулизма относятся симптомы нарушения функции глотания. Они могут проявиться в первые часы после отравления. Пациент жалуется на ощущение «кома» в горле, «царапанья» и боли при глотании. Позже может присоединиться поперхивание.
В случае, если заболевание начинается с поражения нервов, отвечающих за иннервацию мышц зрительного анализатора, то больной предъявляет жалобы на:
- нарушение остроты зрения;
- невозможность чтения (парез аккомодации);
- отмечается расширение зрачков (мидриаз), фоточувствительность;
- косоглазие (страбизм);
- двоение предметов (диплопия);
- нистагм;
- трудность поднять веки (птоз век).
Как правило, диспепсические симптомы отмечаются в течение нескольких часов, офтальмологические нарушения сохраняются несколько дней.
Одновременно отмечается изменение тембра голоса. Он становится низким, глухим, сиплым. Из-за расслабления мягкого неба звучание приобретает гнусавость. У некоторых больных отмечается парез или вялый паралич лицевых мышц. Лицо становится неподвижным, напоминающим гипсовую маску.
Наиболее тяжелыми проявлениями ботулизма являются симптомы ослабления функции мускулатуры, отвечающей за процесс дыхания. Выражается это в неподвижности мышц грудной клетки, отсутствии брюшного дыхания, невозможности естественной очистки дыхательных путей. Остановка дыхания – наиболее частая причина летального исхода.
Ботулизм
Действие ботулотоксина распространяется и на сердечную мышцу. Происходят дистрофические изменения в структуре миокарда. Остановка сердца – вторая по частоте встречаемости причина летального исхода при ботулизме.
Вопрос-ответ
Каковы основные симптомы ботулизма и когда они появляются?
Симптомы ботулизма могут включать слабость, головокружение, двоение в глазах, затрудненное глотание и речь, а также мышечную паралич. Они обычно появляются через 12-36 часов после употребления зараженной пищи, но могут проявляться и в более короткие сроки.
Как можно предотвратить ботулизм в домашних условиях?
Для предотвращения ботулизма важно соблюдать правила консервирования продуктов, включая тщательную стерилизацию банок и использование правильных методов обработки. Также следует избегать употребления домашних консервов, если есть сомнения в их безопасности.
Какова роль медицинской помощи при подозрении на ботулизм?
При подозрении на ботулизм необходимо немедленно обратиться за медицинской помощью. Лечение включает введение антитоксина, который может предотвратить дальнейшее развитие болезни, а также поддерживающую терапию для устранения симптомов и восстановления функций организма.
Советы
СОВЕТ №1
Обратите внимание на сроки хранения продуктов. Ботулизм часто связан с употреблением неправильно консервированных или испорченных продуктов. Убедитесь, что вы храните консервы в соответствии с рекомендациями и не употребляете продукты с истекшим сроком годности.
СОВЕТ №2
Изучите методы домашней консервации. Если вы занимаетесь консервированием самостоятельно, обязательно ознакомьтесь с безопасными методами, такими как использование давления и соблюдение температурных режимов, чтобы предотвратить развитие бактерий, вызывающих ботулизм.
СОВЕТ №3
Будьте внимательны к симптомам. Знайте, что ранние признаки ботулизма могут включать слабость, головокружение, затрудненное дыхание и проблемы с речью. Если вы заметили такие симптомы после употребления пищи, немедленно обратитесь за медицинской помощью.
СОВЕТ №4
Обучите своих близких. Расскажите семье и друзьям о рисках ботулизма и о том, как его предотвратить. Чем больше людей будет осведомлено о безопасных практиках хранения и приготовления пищи, тем ниже риск возникновения заболевания.